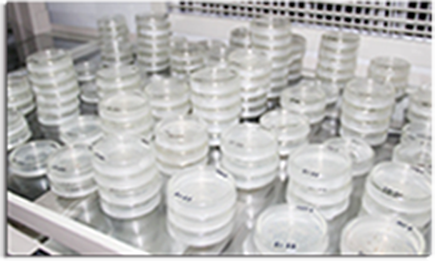
introduction_img-2

什么是淇糖米
— ABOUT ZETANGMI —
“淇糖米”是享受国务院特殊津贴的国家级育种专家江祺祥教授(武育粳之父)率专家团队利用全球最顶尖的生物分子育种技术,苦研数十年而成的一款升糖指数低,富含亚麻酸的高科技功能性大米。
“淇糖米”研发成果后经过长达五年的实验和培育经“农业部稻米及制品质量监督检验测试中心”检测确定各项成分指标稳定后,由“苏州大学附属第三医院”内分泌代谢科的医学专家对“淇糖米”进行了糖鼠实验研究,结果提示:食用普通大米的糖鼠具有如下特点:1、餐后血糖水平、餐化血红蛋白水平、血甘油三酯水平明显降低;2、血清TNF-α(肿瘤坏死因子-α)、IL-6(白介素-6)、CRP(C反应蛋白)等易引起血管硬化的炎症因子水平显著降低;3、胰岛素敏感性明显提高。研究进一步证实:“淇糖米”对糖尿病患者而言,既有利于餐后血糖的控制,又有利于胰岛素功能的保护,更有益于心脑血管并发症的预防。该研究结果提示“淇糖米”对糖尿病患者具有较高的应用价值。

淇糖米之父
— ZETANGMI INVERTOR —
江祺祥:江苏武进人,农民育种专家。现任常州市武进区稻麦育种场水稻育种课题组组长。推广研究员,江苏省第八、九届政协委员,常州市十一、十二、十三届人大代表,武进区十二、十三届人大常委。原本是一个农民出生的种子迷,1974年被选拔到武进稻麦育种场从事专业水稻育种后努力学习理论知识,不断积累、总结实践经验。功夫不负有心人,终于在1980年在江苏省招收1000名农、林、牧业技术人员考试时,被录用为国家干部。通过数十年如一日的艰苦奋斗,南繁北育,先后育成武育粳系列品种(系)十余个,累计推广面积1.5亿多亩,增加社会经济效益100多亿元。
培育的品种多次获重大成果奖,其中国家科技进步二等奖一次,省科技进步一等奖一次,二等奖三次,三等奖一次,江苏省首届农业科技成果转化一等奖一次。其个人分别被评为省和国家有突出贡献的中青年专家,全国农技推广先进,省、市、县各级劳动模范和先进工作者等,享受国务院特殊津贴,并获得常州及武进市政府重奖。







 江苏省临海农场
江苏省临海农场
研发团队
江祺祥教授研发,原常州市武进区稻麦育种场水稻育种课题组组长
 江祺祥:男,江苏武进人,农民育种家。原常州武
进区稻麦育种场水稻育种课题组组长,推广研究员,
江苏省第八、九届政协委员,常州市十一、十二、十
三届人大代表,武进区十二、十三届人大常委。原本
是一个农民出生的种子迷,1974年被选拔到武进稻麦
育种场从事专业水稻育种后努力学习理论知识,不断
积累、总结实践经验。功夫不负有心人,终于在1980
年在江苏省招收1000名农、林、牧业技术人员考试时,
被录用为国家干部。通过数十年如一日的艰苦奋斗,南繁北育,先后育成武育粳系列
品种(系)
江祺祥:男,江苏武进人,农民育种家。原常州武
进区稻麦育种场水稻育种课题组组长,推广研究员,
江苏省第八、九届政协委员,常州市十一、十二、十
三届人大代表,武进区十二、十三届人大常委。原本
是一个农民出生的种子迷,1974年被选拔到武进稻麦
育种场从事专业水稻育种后努力学习理论知识,不断
积累、总结实践经验。功夫不负有心人,终于在1980
年在江苏省招收1000名农、林、牧业技术人员考试时,
被录用为国家干部。通过数十年如一日的艰苦奋斗,南繁北育,先后育成武育粳系列
品种(系)十余个,累计推广面积1.5亿多亩,增加社会经济效益100多亿元。

国务院颁发证书

国家科学技术进步二等奖

国家农业推广先进工作者

江苏省科学技术进步一等奖









使用说明
蒸煮兼可
一天至少2顿,加水比例1:1.3,煮好闷10分钟


浸泡 & 加水
淘米后浸泡30分钟,让米发白口
感更佳,加水比例为1:1.3,烧开 后闷10分钟即可。


一天不低于2餐
女性50-75克,男性75-100克,
生米,一天至少要2餐才能保证 食用效果。


真空包装
运送过程中产生的颠簸会造成真
空包装漏气,属于正常现象,不 用担心。



















